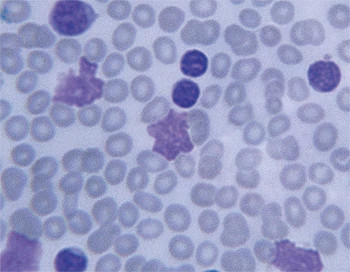
leukemia-cells-large350x272.jpg

New test developed at Dana-Farber/Brigham and Women's Cancer Center speeds treatment decisions for blood cancer patients
For patients with aggressive types of leukemia and other blood cancers, quickly identifying and starting the right treatment can make all the difference.
In a major advance in the care of these patients, physicians at Dana-Farber/Brigham and Women’s Cancer Center (DF/BWCC) have begun using Rapid Heme Panel, a high-tech genetic test that provides, within a matter of days, an unprecedented amount of critical information to aid the choice of treatment.
Developed by Dana-Farber and Brigham and Women’s scientists, Rapid Heme Panel scans DNA from a blood or bone marrow sample using “next-generation” sequencing. The test searches for alterations in 95 genes that are frequently associated with leukemias, myeloproliferative syndromes (MPS), and myeloproliferative neoplasms (MPN), detecting key mutations that determine prognosis and the specific drugs the cancer is most likely to respond to. Cancer DNA contains a unique combination of mutations that drive the cancer’s growth, and, in some cases, make it vulnerable to drugs that target those mutations. The test was launched in August and has been used in more than 100 patients to date.
“This is the best personalized medicine application in hematological oncology,” said Richard Stone, MD, director of the Adult Leukemia Program at Dana-Farber/Brigham and Women’s Cancer Center. “Already, we have been able to put patients on clinical trials by knowing the mutational status of their cancers earlier than ever before.” Certain clinical trials test experimental drugs that home in on specific mutations.
Instead of sending six tubes of blood to different laboratories and waiting about two weeks for the results, Stone said, Rapid Heme Panel tests one tube of blood and returns results in five business days or less. Among other benefits, the test can help cancer specialists quickly determine whether a bone marrow or stem cell transplant is a good option for a sick patient – and when it should be done urgently.
“This gives our clinicians information they did not have before,” said Jeff Golden, MD, chair of Pathology at Brigham and Women’s Hospital. And, he added, the cost of Rapid Heme Panel testing is lower than the cost of separate tests that detect fewer genes.
Jon Aster, MD, PhD, director of Hematopathology at Brigham and Women’s Hospital, and one of the developers of Rapid Heme Panel, noted that the test is based on similar technology to the Profile research study at DF/BWCC, offered to every patient, that uses next-generation sequencing to scan 305 genes potentially associated with a variety of cancers. “We’re looking at 95 genes for blood cancers and returning the results in a time frame that is actionable for our clinicians,” Aster said.
The test is currently being used for adult patients with leukemia, myelodysplastic syndromes (caused by poorly formed or dysfunctional blood cells), and myeloproliferative neoplasms that fill the bone marrow with abnormal blood cells. The DF/BWCC team hopes to expand its use to other blood cancers soon.
“For many of our patients, it is critical to jump on their cancer quickly with an accurate diagnosis and thorough knowledge of the mutations that are driving their malignancy,” said Robert Soiffer, MD, chief, Hematologic Malignancies at Dana-Farber/Brigham and Women’s Cancer Center. “Thanks to in-house testing with the Rapid Heme Panel, we can acquire the information we need to make treatment decisions faster than ever before.”
The Dana-Farber/Brigham and Women’s Cancer Center team that created Rapid-Heme was co-led by Frank Kuo, MD, with critical interpretation by Coleman Lindsley, MD, PhD. The team also includes: Daniel DeAngelo, MD, PhD, Benjamin Ebert, MD, PhD, Ilene Galinsky, RNP, and Michael Kluk, MD, PhD.

Media Contacts
If you are a journalist and have a question about this story, please call 617-632-4090 and ask to speak to a member of the media team, or email media@dfci.harvard.edu.
The Media Team cannot respond to patient inquiries. For more information, please see Contact Us.